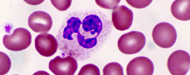
featured project

Density Gradient Separation Media
Molecular biologys classical period began in 1953, with James Watson and Francis Cricks discovery of the double helical structure of DNA. After knowing the structure of DNA, molecular biologists started their scientific journey to find out the mechanisms of genetic replication and role of genes in heredity. Advances in molecular biology are transforming all areas of medical practice and going to become a predominant paradigm of medical science. To be an integral part of this era, HiMedia established its Molecular Biology Department with a focus to develop world-class quality products related to basic and clinical research at an affordable price for the scientists.